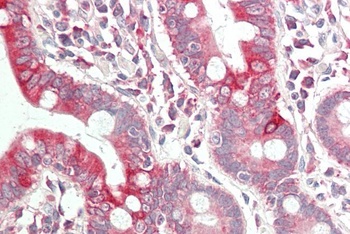
ICAM1 Antibody

You have no items in your shopping cart.
Search results for: 'ICAM-1 (CD54)'
- Icam1 Antibody [orb627892]Featured

ELISA, IHC, WB
Human, Mouse, Rat
Rabbit
Polyclonal
Unconjugated
100 μg, 50 μg - ICAM-1 Antibody [orb1471698]Featured

FC
Human
Rabbit
Monoclonal
Unconjugated
50 μg, 100 μg, 500 μg, 10 μg - CD54 Antibody [orb214077]
IHC, WB
Human, Mouse
Rabbit
Polyclonal
Unconjugated
30 μl, 100 μl, 200 μl, 50 μl - Human ICAM-1 Protein, mFc Tag [orb689412]Featured

The purity of the protein is greater than 95% as determined by SDS-PAGE and Coomassie blue staining.
The protein has a predicted molecular mass of 75.7 kDa after removal of the signal peptide.The apparent molecular mass of ICAM-1-mFc is approximately 90-120 kDa due to glycosylation.
Mammalian
50 μg, 100 μg, 10 μg